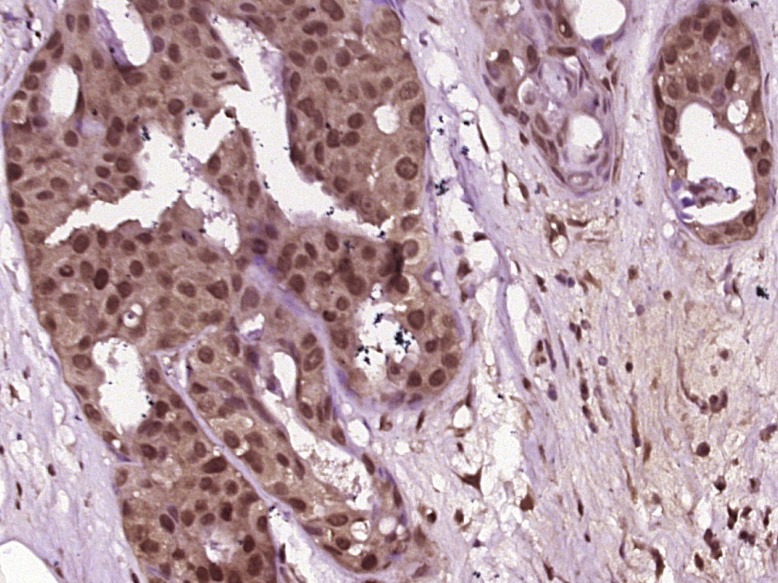

您的购物车当前为空
您的购物车当前为空
Anti-Phospho-JNK1/2/3 (Thr 183, Tyr185) Polyclonal Antibody
Synonyms: Tyrosine protein kinase JAK1, Stress activated protein kinase JNK1, SAPK1, SAPK gamma, SAPK 1, Protein kinase, mitogen-activated, 8, Protein kinase JNK1, PRKM8, PRKM 8, p-JNK1/2/3 (Thr, Tyr185), p-JNK1/2/3 (T, Y185), p54 gamma, MK10, MK09, MK08, Mitogen activated protein kinase 8, MAPK8, MAPK 8, MAP kinase 8, JNK21B1/2, JNK1A2, JNK1/2/3 (p-Thr, p-Tyr185), JNK1/2/3 (p-T, p-Y185), JNK 46, JNK 1, JNK, JAK1A, JAK 1A, EC 2.7.11.24, C-JUN kinase 1, c Jun N terminal kinase 1, AI849689Anti-Phospho-JNK1/2/3 (Thr 183, Tyr185) Polyclonal Antibody 是一种 Rabbit 抗体,靶向 Phospho-JNK1/2/3 (Thr 183, Tyr185)。Anti-Phospho-JNK1/2/3 (Thr 183, Tyr185) Polyclonal Antibody 可用于 FCM,IF,IHC-Fr,IHC-P,WB。
Anti-Phospho-JNK1/2/3 (Thr 183, Tyr185) Polyclonal Antibody
一键复制产品信息别名 Tyrosine protein kinase JAK1, Stress activated protein kinase JNK1, SAPK1, SAPK gamma, SAPK 1, Protein kinase, mitogen-activated, 8, Protein kinase JNK1, PRKM8, PRKM 8, p-JNK1/2/3 (Thr, Tyr185), p-JNK1/2/3 (T, Y185), p54 gamma, MK10, MK09, MK08, Mitogen activated protein kinase 8, MAPK8, MAPK 8, MAP kinase 8, JNK21B1/2, JNK1A2, JNK1/2/3 (p-Thr, p-Tyr185), JNK1/2/3 (p-T, p-Y185), JNK 46, JNK 1, JNK, JAK1A, JAK 1A, EC 2.7.11.24, C-JUN kinase 1, c Jun N terminal kinase 1, AI849689
Anti-Phospho-JNK1/2/3 (Thr 183, Tyr185) Polyclonal Antibody 是一种 Rabbit 抗体,靶向 Phospho-JNK1/2/3 (Thr 183, Tyr185)。Anti-Phospho-JNK1/2/3 (Thr 183, Tyr185) Polyclonal Antibody 可用于 FCM,IF,IHC-Fr,IHC-P,WB。
| 规格 | 价格 | 库存 | 数量 |
|---|---|---|---|
| 50 μL | ¥ 1,160 | 5日内发货 | |
| 100 μL | ¥ 1,970 | 5日内发货 | |
| 200 μL | ¥ 2,780 | 5日内发货 |
TargetMol的所有产品仅用作科学研究或药证申报,不能被用于人体,我们不向个人提供产品和服务。请您遵守承诺用途,不得违反法律法规规定用于任何其他用途。
产品介绍
| 产品描述 | Anti-Phospho-JNK1/2/3 (Thr 183, Tyr185) Polyclonal Antibody is a Rabbit antibody targeting Phospho-JNK1/2/3 (Thr 183, Tyr185). Anti-Phospho-JNK1/2/3 (Thr 183, Tyr185) Polyclonal Antibody can be used in FCM,IF,IHC-Fr,IHC-P,WB. |
| 别名 | Tyrosine protein kinase JAK1, Stress activated protein kinase JNK1, SAPK1, SAPK gamma, SAPK 1, Protein kinase, mitogen-activated, 8, Protein kinase JNK1, PRKM8, PRKM 8, p-JNK1/2/3 (Thr, Tyr185), p-JNK1/2/3 (T, Y185), p54 gamma, MK10, MK09, MK08, Mitogen activated protein kinase 8, MAPK8, MAPK 8, MAP kinase 8, JNK21B1/2, JNK1A2, JNK1/2/3 (p-Thr, p-Tyr185), JNK1/2/3 (p-T, p-Y185), JNK 46, JNK 1, JNK, JAK1A, JAK 1A, EC 2.7.11.24, C-JUN kinase 1, c Jun N terminal kinase 1, AI849689 |
| Ig Type | IgG |
| 反应种属 | Human,Mouse,Rat (predicted:Dog,Pig,Cow) |
| 验证活性 | 1. Paraformaldehyde-fixed, paraffin embedded (Human breast cancer); Antigen retrieval by boiling in sodium citrate buffer (pH6.0) for 15 min; Block endogenous peroxidase by 3% hydrogen peroxide for 20 min; Blocking buffer (normal goat serum) at 37°C for 30 min; Antibody incubation with (MAPK8) Polyclonal Antibody, Unconjugated (TMAB-01447) at 1:400 overnight at 4°C, followed by operating according to SP Kit (Rabbit) instructions and DAB staining. 2. Blank control: mouse splenocytes (blue) Isotype Control Antibody: Rabbit Igg (orange); Secondary Antibody: Goat anti-rabbit IgG-FITC (white blue), Dilution: 1:100 in 1 X PBS containing 0.5% BSA; Primary Antibody Dilution: 1 μL in 100 μL 1X PBS containing 0.5% BSA (green). 3. Paraformaldehyde-fixed, paraffin embedded (Mouse brain); Antigen retrieval by boiling in sodium citrate buffer (pH6.0) for 15 min; Block endogenous peroxidase by 3% hydrogen peroxide for 20 min; Blocking buffer (normal goat serum) at 37°C for 30 min; Antibody incubation with (JNK1 + 2 + 3 (Thr183+Tyr185)) Polyclonal Antibody, Unconjugated (TMAB-01447) at 1:500 overnight at 4°C, followed by a conjugated secondary for 20 min and DAB staining. 4. Paraformaldehyde-fixed, paraffin embedded (rat brain); Antigen retrieval by boiling in sodium citrate buffer (pH6.0) for 15 min; Block endogenous peroxidase by 3% hydrogen peroxide for 20 min; Blocking buffer (normal goat serum) at 37°C for 30 min; Antibody incubation with (phospho-JNK1 + 2 + 3 (Thr183+Tyr185)) Polyclonal Antibody, Unconjugated (TMAB-01447) at 1:200 overnight at 4°C, followed by operating according to SP Kit (Rabbit) instructionsand DAB staining. 5. Blank control: Jurkat. Primary Antibody (green line): Rabbit Anti-phospho-JNK1 + 2 + 3 (Thr183+Tyr185) antibody (TMAB-01447) Dilution: 1 μg/10^6 cells; Isotype Control Antibody (orange line): Rabbit IgG. Secondary Antibody: Goat anti-rabbit IgG-AF647 Dilution: 1 μg/test. Protocol The cells were fixed with 4% PFA (10 min at room temperature) and then permeabilized with 90% ice-cold methanol for 20 min at-20°C. The cells were then incubated in 5% BSA to block non-specific protein-protein interactions for 30 min at room temperature. Cells stained with Primary Antibody for 30 min at room temperature. The secondary antibody used for 40 min at room temperature. 6. Blank control: Jurkat. Primary Antibody (green line): Rabbit Anti-phospho-JNK1 + 2 + 3 (Thr183+Tyr185) antibody (TMAB-01447) Dilution: 1 μg/10^6 cells; Isotype Control Antibody (orange line): Rabbit IgG. Secondary Antibody: Goat anti-rabbit IgG-AF647 Dilution: 1 μg/test. Protocol The cells were fixed with 4% PFA (10 min at room temperature) and then permeabilized with 90% ice-cold methanol for 20 min at-20°C. The cells were then incubated in 5% BSA to block non-specific protein-protein interactions for 30 min at room temperature. Cells stained with Primary Antibody for 30 min at room temperature. The secondary antibody used for 40 min at room temperature. 7. Paraformaldehyde-fixed, paraffin embedded (rat cerebellum); Antigen retrieval by boiling in sodium citrate buffer (pH6.0) for 15 min; Block endogenous peroxidase by 3% hydrogen peroxide for 20 min; Blocking buffer (normal goat serum) at 37°C for 30 min; Antibody incubation with (phospho-JNK1 + 2 + 3 (Thr183+Tyr185)) Polyclonal Antibody, Unconjugated (TMAB-01447) at 1:200 overnight at 4°C, followed by operating according to SP Kit (Rabbit) instructionsand DAB staining. 8. Paraformaldehyde-fixed, paraffin embedded (human brain); Antigen retrieval by boiling in sodium citrate buffer (pH6.0) for 15 min; Block endogenous peroxidase by 3% hydrogen peroxide for 20 min; Blocking buffer (normal goat serum) at 37°C for 30 min; Antibody incubation with (phospho-JNK1 + 2 + 3 (Thr183+Tyr185)) Polyclonal Antibody, Unconjugated (TMAB-01447) at 1:200 overnight at 4°C, followed by operating according to SP Kit (Rabbit) instructionsand DAB staining. 9. Paraformaldehyde-fixed, paraffin embedded (human gastric carcinoma); Antigen retrieval by boiling in sodium citrate buffer (pH6.0) for 15 min; Block endogenous peroxidase by 3% hydrogen peroxide for 20 min; Blocking buffer (normal goat serum) at 37°C for 30 min; Antibody incubation with (phospho-JNK1 + 2 + 3 (Thr183+Tyr185)) Polyclonal Antibody, Unconjugated (TMAB-01447) at 1:200 overnight at 4°C, followed by operating according to SP Kit (Rabbit) instructionsand DAB staining. 10. Paraformaldehyde-fixed, paraffin embedded (mouse brain); Antigen retrieval by boiling in sodium citrate buffer (pH6.0) for 15 min; Block endogenous peroxidase by 3% hydrogen peroxide for 20 min; Blocking buffer (normal goat serum) at 37°C for 30 min; Antibody incubation with (phospho-JNK1 + 2 + 3 (Thr183+Tyr185)) Polyclonal Antibody, Unconjugated (TMAB-01447) at 1:200 overnight at 4°C, followed by operating according to SP Kit (Rabbit) instructionsand DAB staining. 11. Paraformaldehyde-fixed, paraffin embedded (mouse kidney); Antigen retrieval by boiling in sodium citrate buffer (pH6.0) for 15 min; Block endogenous peroxidase by 3% hydrogen peroxide for 20 min; Blocking buffer (normal goat serum) at 37°C for 30 min; Antibody incubation with (phospho-JNK1 + 2 + 3 (Thr183+Tyr185)) Polyclonal Antibody, Unconjugated (TMAB-01447) at 1:200 overnight at 4°C, followed by operating according to SP Kit (Rabbit) instructionsand DAB staining. 12. Paraformaldehyde-fixed, paraffin embedded (mouse brain); Antigen retrieval by boiling in sodium citrate buffer (pH6.0) for 15 min; Block endogenous peroxidase by 3% hydrogen peroxide for 20 min; Blocking buffer (normal goat serum) at 37°C for 30 min; Antibody incubation with (phospho-JNK1 + 2 + 3 (Thr183+Tyr185)) Polyclonal Antibody, Unconjugated (TMAB-01447) at 1:200 overnight at 4°C, followed by operating according to SP Kit (Rabbit) instructionsand DAB staining. 13. Paraformaldehyde-fixed, paraffin embedded (mouse cerebellum); Antigen retrieval by boiling in sodium citrate buffer (pH6.0) for 15 min; Block endogenous peroxidase by 3% hydrogen peroxide for 20 min; Blocking buffer (normal goat serum) at 37°C for 30 min; Antibody incubation with (phospho-JNK1 + 2 + 3 (Thr183+Tyr185)) Polyclonal Antibody, Unconjugated (TMAB-01447) at 1:200 overnight at 4°C, followed by operating according to SP Kit (Rabbit) instructionsand DAB staining. 14. Paraformaldehyde-fixed, paraffin embedded (mouse heart); Antigen retrieval by boiling in sodium citrate buffer (pH6.0) for 15 min; Block endogenous peroxidase by 3% hydrogen peroxide for 20 min; Blocking buffer (normal goat serum) at 37°C for 30 min; Antibody incubation with (phospho-JNK1 + 2 + 3 (Thr183+Tyr185)) Polyclonal Antibody, Unconjugated (TMAB-01447) at 1:200 overnight at 4°C, followed by operating according to SP Kit (Rabbit) instructionsand DAB staining. 15. Paraformaldehyde-fixed, paraffin embedded (rat kidney); Antigen retrieval by boiling in sodium citrate buffer (pH6.0) for 15 min; Block endogenous peroxidase by 3% hydrogen peroxide for 20 min; Blocking buffer (normal goat serum) at 37°C for 30 min; Antibody incubation with (phospho-JNK1 + 2 + 3 (Thr183+Tyr185)) Polyclonal Antibody, Unconjugated (TMAB-01447) at 1:200 overnight at 4°C, followed by operating according to SP Kit (Rabbit) instructionsand DAB staining. 16. Paraformaldehyde-fixed, paraffin embedded (rat cerebellum); Antigen retrieval by boiling in sodium citrate buffer (pH6.0) for 15 min; Block endogenous peroxidase by 3% hydrogen peroxide for 20 min; Blocking buffer (normal goat serum) at 37°C for 30 min; Antibody incubation with (phospho-JNK1 + 2 + 3 (Thr183+Tyr185)) Polyclonal Antibody, Unconjugated (TMAB-01447) at 1:200 overnight at 4°C, followed by operating according to SP Kit (Rabbit) instructionsand DAB staining. 17. Paraformaldehyde-fixed, paraffin embedded (human colon carcinoma); Antigen retrieval by boiling in sodium citrate buffer (pH6.0) for 15 min; Block endogenous peroxidase by 3% hydrogen peroxide for 20 min; Blocking buffer (normal goat serum) at 37°C for 30 min; Antibody incubation with (phospho-JNK1 + 2 + 3 (Thr183+Tyr185)) Polyclonal Antibody, Unconjugated (TMAB-01447) at 1:200 overnight at 4°C, followed by operating according to SP Kit (Rabbit) instructionsand DAB staining. 18. Blank control: K562. Primary Antibody (green line): Rabbit Anti-phospho-JNK1 + 2 + 3 (Thr183+Tyr185) antibody (TMAB-01447) Dilution: 1 μg/10^6 cells; Isotype Control Antibody (orange line): Rabbit IgG. Secondary Antibody: Goat anti-rabbit IgG-FITC Dilution: 1 μg/test. Protocol The cells were fixed with 4% PFA (10 min at room temperature) and then permeabilized with 90% ice-cold methanol for 20 min at-20°C. The cells were then incubated in 5% BSA to block non-specific protein-protein interactions for 30 min at room temperature. Cells stained with Primary Antibody for 30 min at room temperature. The secondary antibody used for 40 min at room temperature. 19. Blank control: K562. Primary Antibody (green line): Rabbit Anti-phospho-JNK1 + 2 + 3 (Thr183+Tyr185) antibody (TMAB-01447) Dilution: 1 μg/10^6 cells; Isotype Control Antibody (orange line): Rabbit IgG. Secondary Antibody: Goat anti-rabbit IgG-FITC Dilution: 1 μg/test. Protocol The cells were fixed with 4% PFA (10 min at room temperature) and then permeabilized with 90% ice-cold methanol for 20 min at-20°C. The cells were then incubated in 5% BSA to block non-specific protein-protein interactions for 30 min at room temperature. Cells stained with Primary Antibody for 30 min at room temperature. The secondary antibody used for 40 min at room temperature. 20. Sample: Lane 1: Cerebrum (Rat) Lysate at 40 μg Lane 2: Cerebrum (Mouse) Lysate at 40 μg Lane 3: Cerebellum (Rat) Lysate at 40 μg Lane 4: Cerebellum (Mouse) Lysate at 40 μg Lane 5: Heart (Rat) Lysate at 40 μg Lane 6: Heart (Mouse) Lysate at 40 μg Lane 7: Kidney (Mouse) Lysate at 40 μg Primary: Anti-phospho-JNK1 + 2 + 3 (Thr183+Tyr185) (TMAB-01447) at 1/1000 dilution Secondary: IRDye800CW Goat Anti-Rabbit IgG at 1/20000 dilution Predicted band size: 46/54 kDa Observed band size: 52 kDa 21. Paraformaldehyde-fixed, paraffin embedded (mouse brain); Antigen retrieval by boiling in sodium citrate buffer (pH6.0) for 15 min; Block endogenous peroxidase by 3% hydrogen peroxide for 20 min; Blocking buffer (normal goat serum) at 37°C for 30 min; Antibody incubation with (phospho-JNK1 + 2 + 3 (Thr183+Tyr185)) Polyclonal Antibody, Unconjugated (TMAB-01447) at 1:200 overnight at 4°C, followed by operating according to SP Kit (Rabbit) instructionsand DAB staining. 22. Paraformaldehyde-fixed, paraffin embedded (rat brain); Antigen retrieval by boiling in sodium citrate buffer (pH6.0) for 15 min; Block endogenous peroxidase by 3% hydrogen peroxide for 20 min; Blocking buffer (normal goat serum) at 37°C for 30 min; Antibody incubation with (phospho-JNK1 + 2 + 3 (Thr183+Tyr185)) Polyclonal Antibody, Unconjugated (TMAB-01447) at 1:200 overnight at 4°C, followed by operating according to SP Kit (Rabbit) instructionsand DAB staining. 23. Sample: Heart (Mouse) Lysate at 40 μg Heart (Rat) Lysate at 40 μg Primary: Anti-phospho-JNK1+2+3 (Thr183+Tyr185) (TMAB-01447) at 1/500 dilution Secondary: IRDye800CW Goat Anti-Rabbit IgG at 1/20000 dilution Predicted band size: 46/54 kDa Observed band size: 54 kDa 24. Paraformaldehyde-fixed, paraffin embedded (rat brain); Antigen retrieval by boiling in sodium citrate buffer (pH6.0) for 15 min; Block endogenous peroxidase by 3% hydrogen peroxide for 20 min; Blocking buffer (normal goat serum) at 37°C for 30 min; Antibody incubation with (phospho-JNK1 + 2 + 3 (Thr183+Tyr185)) Polyclonal Antibody, Unconjugated (TMAB-01447) at 1:200 overnight at 4°C, followed by operating according to SP Kit (Rabbit) instructionsand DAB staining. 25. Paraformaldehyde-fixed, paraffin embedded (rat brain tissue); Antigen retrieval by boiling in sodium citrate buffer (pH6.0) for 15 min; Block endogenous peroxidase by 3% hydrogen peroxide for 20 min; Blocking buffer (normal goat serum) at 37°C for 30 min; Antibody incubation with (MAPK8) Polyclonal Antibody, Unconjugated (TMAB-01447) at 1:400 overnight at 4°C, followed by operating according to SP Kit (Rabbit) instructionsand DAB staining. 26. Paraformaldehyde-fixed, paraffin embedded (human brain glioma); Antigen retrieval by boiling in sodium citrate buffer (pH6.0) for 15 min; Block endogenous peroxidase by 3% hydrogen peroxide for 20 min; Blocking buffer (normal goat serum) at 37°C for 30 min; Antibody incubation with (MAPK8) Polyclonal Antibody, Unconjugated (TMAB-01447) at 1:400 overnight at 4°C, followed by operating according to SP Kit (Rabbit) instructionsand DAB staining. |
| 应用 | FCMIFIHC-FrIHC-PWB |
| 推荐剂量 | WB: 1:500-2000; IHC-P: 1:100-500; IHC-Fr: 1:100-500; IF: 1:100-500; FCM: 1μg /test |
| 抗体种类 | Polyclonal |
| 宿主来源 | Rabbit |
| 亚细胞定位 | Cytoplasm. Nucleus. |
| 构建方式 | Polyclonal Antibody |
| 纯化方式 | Protein A purified |
| 性状 | Liquid |
| 缓冲液 | 0.01M TBS (pH7.4) with 1% BSA, 0.02% Proclin300 and 50% Glycerol. |
| 浓度 | 1 mg/mL |
| 研究背景 | phosphorylated at the Thr-Pro-Tyr phosphorylation motif instead of the characteristic MAP kinase Thr-Glu-Tyr motif. JNK2 (p54a, SAPK1a), along with JNK1 and JNK3, is thought to play an important role in nuclear signal transduction through its environmental stress activation and subsequent phosphorylation of the nuclear transcription factor p53. |
| 免疫原 | KLH conjugated Synthesised phosphopeptide: human JNK1 around the phosphorylation site of Thr183/Tyr185 |
| 抗原种属 | Human |
| 基因名称 | MAPK8 |
| 基因ID | |
| 蛋白名称 | Mitogen-activated protein kinase 8 |
| Uniprot ID | |
| 研究领域 | MAPK pathway,TLR Signaling,MAPK Pathway |
| 功能 | Serine/threonine-protein kinase involved in various processes such as cell proliferation, differentiation, migration, transformation and programmed cell death. Extracellular stimuli such as proinflammatory cytokines or physical stress stimulate the stress-activated protein kinase/c-Jun N-terminal kinase (SAP/JNK) signaling pathway. In this cascade, two dual specificity kinases MAP2K4/MKK4 and MAP2K7/MKK7 phosphorylate and activate MAPK8/JNK1. In turn, MAPK8/JNK1 phosphorylates a number of transcription factors, primarily components of AP-1 such as JUN, JDP2 and ATF2 and thus regulates AP-1 transcriptional activity. Phosphorylates the replication licensing factor CDT1, inhibiting the interaction between CDT1 and the histone H4 acetylase HBO1 to replication origins. Loss of this interaction abrogates the acetylation required for replication initiation. Promotes stressed cell apoptosis by phosphorylating key regulatory factors including p53/TP53 and Yes-associates protein YAP1. In T-cells, MAPK8 and MAPK9 are required for polarized differentiation of T-helper cells into Th1 cells. Contributes to the survival of erythroid cells by phosphorylating the antagonist of cell death BAD upon EPO stimulation. Mediates starvation-induced BCL2 phosphorylation, BCL2 dissociation from BECN1, and thus activation of autophagy. Phosphorylates STMN2 and hence regulates microtubule dynamics, controlling neurite elongation in cortical neurons. In the developing brain, through its cytoplasmic activity on STMN2, negatively regulates the rate of exit from multipolar stage and of radial migration from the ventricular zone. Phosphorylates several other substrates including heat shock factor protein 4 (HSF4), the deacetylase SIRT1, ELK1, or the E3 ligase ITCH. |
| 分子量 | Theoretical: 42 kDa. Actual: 53 kDa. |
| 储存方式 | Store at -20°C or -80°C for 12 months. Avoid repeated freeze-thaw cycles. |
| 运输方式 | Shipping with blue ice. |





 还可以
还可以
 |
|